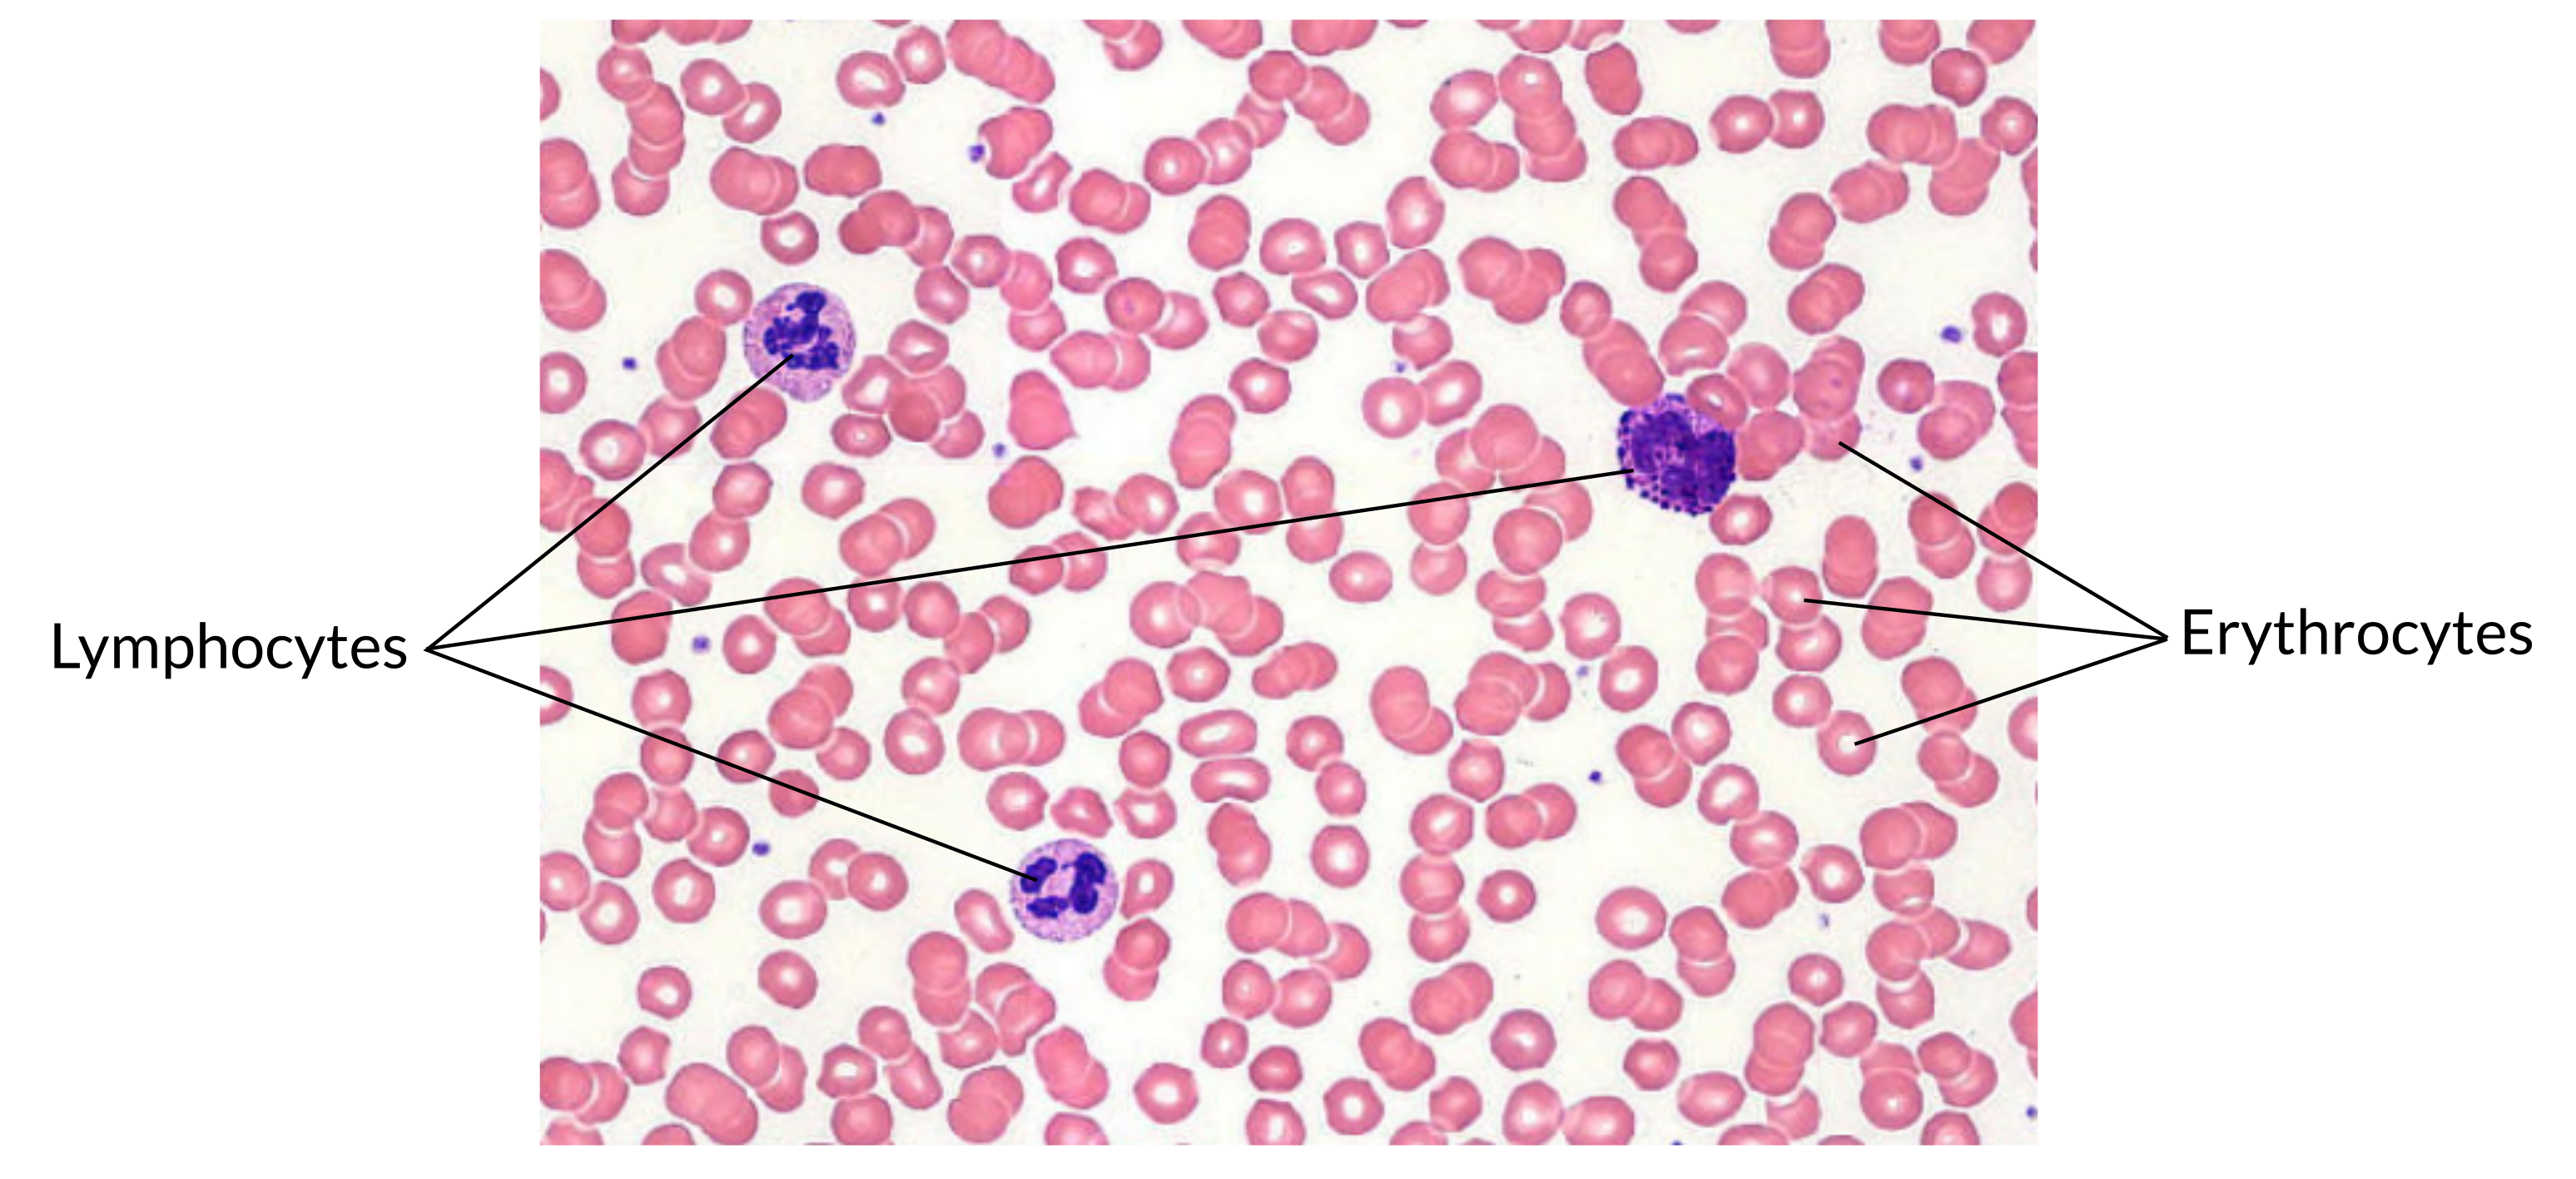
<p><strong>What is a picture example of blood tissue?</strong></p>

Tissue Pictures to know for Quiz on 10/27
1/18
There's no tags or description
Looks like no tags are added yet.
Name | Mastery | Learn | Test | Matching | Spaced |
|---|
No study sessions yet.
19 Terms

Picture example of nervous tissue:
What is a picture example of nervous tissue?


Picture example of stratified squamous epithelium tissue:
What is a picture example of stratified squamous epithelium tissue?


Picture example of skeletal muscle tissue:
What is a picture example of skeletal muscle tissue?


Picture example of hyaline cartilage tissue:
What is a picture example of hyaline cartilage tissue?


Picture example of dense connective tissue:
What is a picture example of dense connective tissue?


Picture example of simple squamous tissue:
What is a picture example of simple squamous tissue?


Picture example of areolar connective tissue:
What is a picture example of areolar connective tissue?


Picture example of adipose tissue:
What is a picture example of adipose tissue?


Picture example of pseudostratified epithelium tissue:
What is a picture example pseudostratified columnar epithelium tissue?


Picture example of a simple cuboidal epithelium tissue:
What is a picture example of a simple cuboidal epithelium tissue?


Picture example of simple columnar epithelium tissue:
What is a picture example simple columnar epithelium?


Picture example of bone tissue:
What is a picture example of bone tissue?


Picture example of cardiac muscle tissue:
What is a picture example of cardiac muscle tissue?


Picture example of elastic cartilage tissue:
What is a picture example of elastic cartilage tissue?


Picture example of fibrocartilage tissue:
What is a picture example of fibrocartilage tissue?


Picture example of smooth muscle tissue:
What is a picture example of smooth muscle tissue?


Picture example of blood tissue:
What is a picture example of blood tissue?

Picture example of reticular connective tissue:
What is a picture example of reticular connective tissue?


Picture example of skeletal, cardiac and smooth muscle tissue:
What is a picture example of skeletal, cardiac and smooth muscle tissue?
